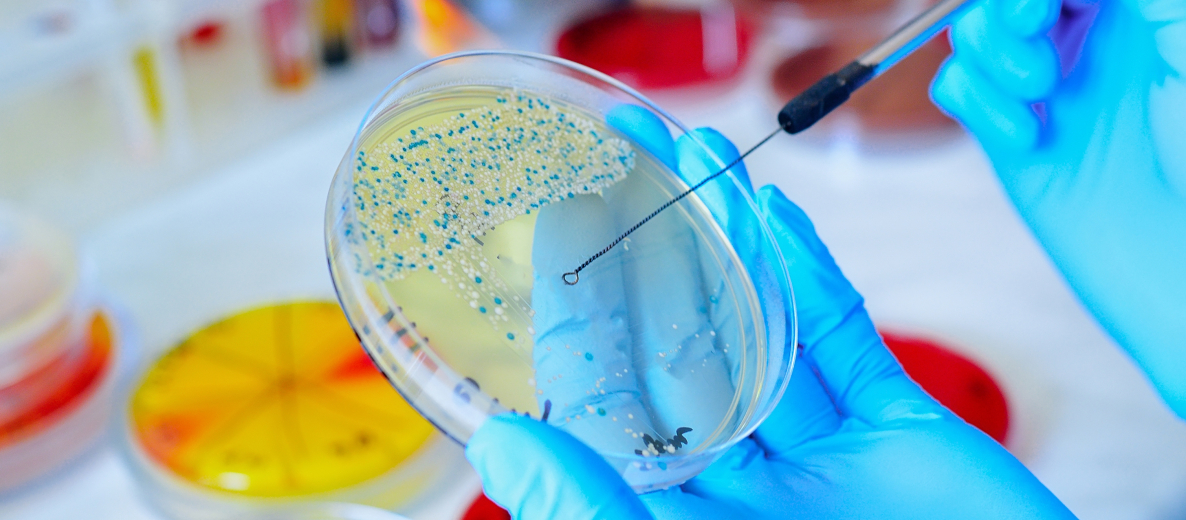
Szalka Petriego

Urząd Patentowy RP przyznał patent na innowacyjny środek antybakteryjny zespołowi badaczy z Międzyuczelnianego Wydziału Biotechnologii Uniwersytetu Gdańskiego i Gdańskiego Uniwersytetu Medycznego, Wydziału Chemii Uniwersytetu Gdańskiego oraz Politechniki Gdańskiej.
Nowo opracowany preparat wykazuje skuteczność w zwalczaniu pałeczki ropy błękitnej (Pseudomonas aeruginosa). To szczególnie niebezpieczna bakteria w środowisku szpitalnym ze względu na jej wysoką oporność na antybiotyki. Co więcej, działa "podstępnie", bowiem patogen występuje w środowisku i u człowieka bez wywoływania choroby, a staje się groźny dopiero przy osłabionym układzie odpornościowym, czyli np. u pacjentów z chorobami przewlekłymi, z ciężkimi urazami lub osób starszych.
Nowy preparat opiera się na nanocząstkach srebra i naftochinonu, który działa poprzez hamowanie wzrostu oraz aktywne zabijanie komórek bakterii.
– Nasz preparat wykorzystuje zjawisko synergii srebra i naftochinonów, czyli wzajemnego zwiększania aktywności przeciwbakteryjnej obu składników. Dzięki synergii bardzo niskie dawki srebra i naftochinonu, które same w sobie nie działają, po połączeniu wykazują silne działanie bakteriobójcze – wyjaśnia kierownik zespołu, dr Marta Krychowiak-Maśnicka z Międzyuczelnianego Wydziału Biotechnologii UG i GUMed, która kierowała zespołem.
Badaczka podkreśla również, że takie synergistyczne podejście pomaga ograniczać rozwój oporności bakterii i wydłuża przydatność substancji w terapii zakażeń. Co więcej, jak dodaje dr Krychowiak-Maśnicka, wykorzystanie nanocząstek srebra to innowacyjna i mniej toksyczna alternatywa dla tradycyjnych soli srebra
W skład interdyscyplinarnego zespołu, który otrzymał już siódmy patent dotyczący środków zwalczających Pseudomonas aeruginosa, poza dr Martą Krychowiak-Maśnicką wchodzą: prof. Aleksandra Królicka z Zakładu Badania Związków Biologicznie Czynnych, także z Międzyuczelnianego Wydziału Biotechnologii UG i GUMed, dr Aleksandra Bielicka-Giełdoń z Wydziału Chemii UG oraz dr Ewa Paluszkiewicz z Politechniki Gdańskiej.
Jak informuje dr Krychowiak-Maśnicka, obecnie zespół prowadzi dalsze badania nad mechanizmem synergii oraz poszukuje partnera biznesowego, który umożliwi wdrożenie rozwiązania w praktyce klinicznej.
Źródło: Polska Agencja Prasowa (PAP)